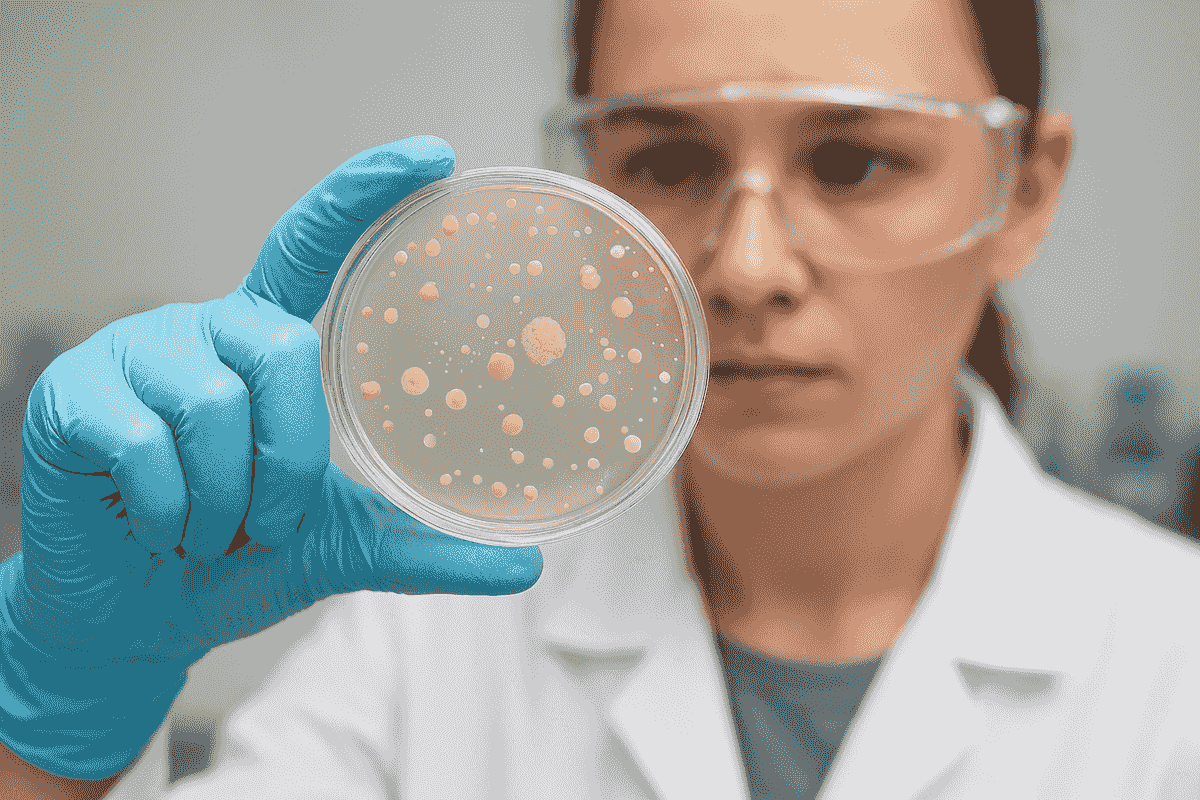
Section image
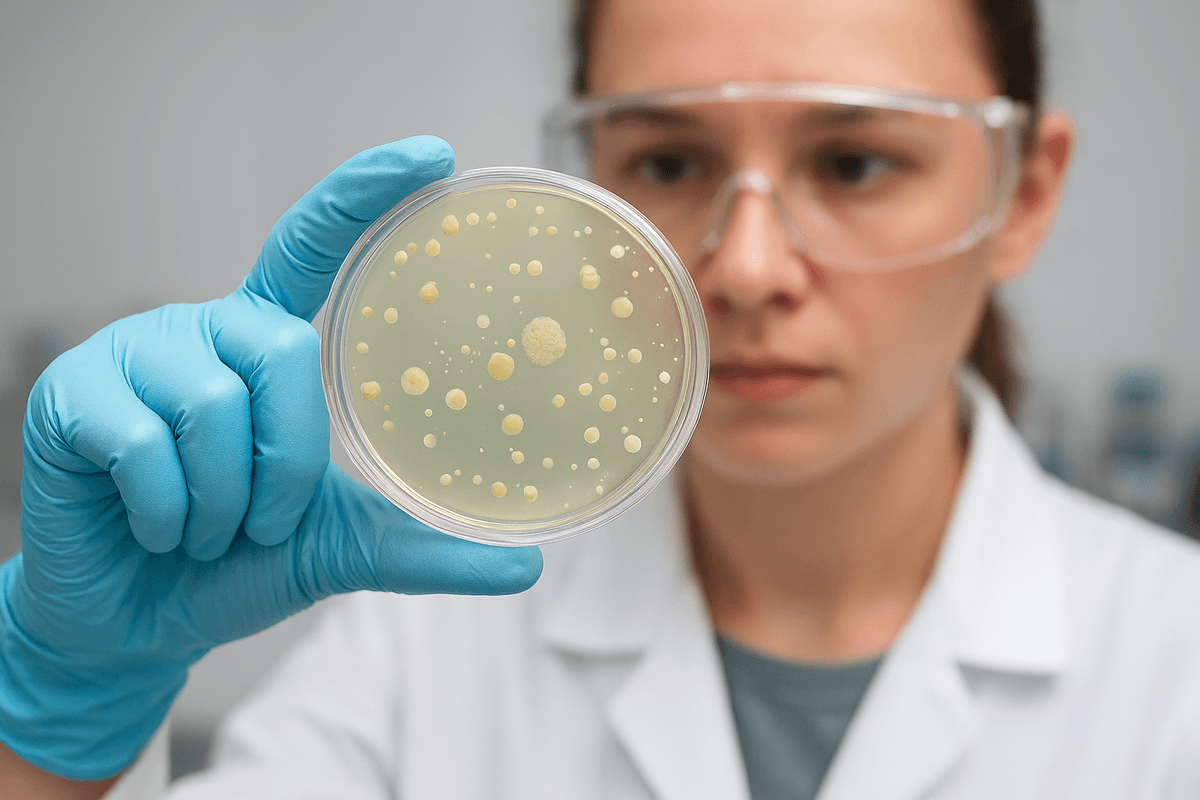
Section image

from China, for the World
for Superior Biology Services since 2000
- Products
- All Products
- Custom Services
- Catalog Products
- Innovative Systems
- Nucleic Acid Related
- Natural Compounds
- Enzymes
- POCT
- 6 POCT Platforms
- LAMP
- RPA
- CRISPR
- Freeze-Drying System
- Lateral Flow System
- DNA-Free Enzymes
- Pathogen Detection
- About
- About SBS
- Achievements
- Ecosystem
- Legal Statement
- …
- Products
- All Products
- Custom Services
- Catalog Products
- Innovative Systems
- Nucleic Acid Related
- Natural Compounds
- Enzymes
- POCT
- 6 POCT Platforms
- LAMP
- RPA
- CRISPR
- Freeze-Drying System
- Lateral Flow System
- DNA-Free Enzymes
- Pathogen Detection
- About
- About SBS
- Achievements
- Ecosystem
- Legal Statement
from China, for the World
for Superior Biology Services since 2000
- Products
- All Products
- Custom Services
- Catalog Products
- Innovative Systems
- Nucleic Acid Related
- Natural Compounds
- Enzymes
- POCT
- 6 POCT Platforms
- LAMP
- RPA
- CRISPR
- Freeze-Drying System
- Lateral Flow System
- DNA-Free Enzymes
- Pathogen Detection
- About
- About SBS
- Achievements
- Ecosystem
- Legal Statement
- …
- Products
- All Products
- Custom Services
- Catalog Products
- Innovative Systems
- Nucleic Acid Related
- Natural Compounds
- Enzymes
- POCT
- 6 POCT Platforms
- LAMP
- RPA
- CRISPR
- Freeze-Drying System
- Lateral Flow System
- DNA-Free Enzymes
- Pathogen Detection
- About
- About SBS
- Achievements
- Ecosystem
- Legal Statement
Synthetic Biology
We provide end-to-end solutions in strain development, process optimization, extraction & purification, and scale-up production to help your biotech innovations reach the market faster.
Over 25 Years Of Excellence In Synthetic Biology
Founded in 2000, SBS Genetech has focused on advancing synthetic biotechnology. From our origins in gene synthesis, we have grown into a full-spectrum partner, offering end-to-end expertise in Strain Development, Process Optimization, Extraction & Purification, and Scale-up Production.
Strain Development
We specialize in advanced microbial screening and metabolic engineering to create robust, high‑performing strains tailored to your project needs. From rational design to adaptive evolution, our strain development platform ensures optimized productivity, stability, and scalability for diverse synthetic biology applications.

Process Optimization
Our team delivers high‑yield fermentation strategies through systematic optimization of culture conditions, media composition, and bioprocess parameters. By combining data‑driven insights with state‑of‑the‑art bioreactors, we maximize efficiency, reduce costs, and accelerate the transition from laboratory research to industrial application.

Extraction & Purification
We provide reliable downstream processing solutions to ensure product purity and consistency. Leveraging industrial‑grade centrifugation, chromatography, and filtration technologies, our purification workflows are designed to handle both complex biomolecules and large‑volume production, guaranteeing reproducible quality for research and commercial use.

Scale-up Production
From lab‑scale validation to pilot and full industrial manufacturing, we offer seamless scale‑up services. Our facilities are equipped with modern stainless‑steel fermenters and integrated downstream systems, enabling smooth technology transfer and consistent performance at every stage of production. This ensures your innovations are ready for market deployment with confidence.
Why Choose Us
Leveraging our strong local platform in China, we help you reduce project timelines by at least 30% and cut costs by over 50%, while ensuring seamless experimental validation and rapid scale-up to production.
Our facilities cover the full spectrum of fermentation needs:
- Lab-scale platform: 5L to 100L fermenters
- Pilot-scale platform: 100L to 2000L fermenters
- Scale-up validation: customized according to your requirements
Every project is supported by engineers with 10+ years of hands-on experience, backed by advanced fermentation monitoring technologies such as near-infrared (NIR) and Raman spectroscopy, enabling truly precise and controlled bioprocessing.
To date, we have successfully delivered over 50 fermentation projects and products. Among them, the largest has already been scaled up to nearly 400 m³ industrial fermentation, demonstrating our proven capability and reliability.
Our Technology In Action
Successfully Co‑incubated The Synthetic Biology Brand Genvera Labs

About SBS Genetech
Founded in 2000, SBS Genetech is a global leader in biotechnology, providing innovative solutions for life science research and medical development. Our products are trusted by researchers in over 60 countries and have been featured in thousands of publications, including Science, Cell, and other top-tier journals.
At SBS Genetech, we remain committed to pushing scientific boundaries through cutting-edge technologies and exceptional service, empowering researchers worldwide to achieve their most ambitious goals.
25+
years of experience in biotech
60+
countries served worldwide
12K+
publications cite our products
30K+
products in our portfolio

SBS Genetech is recognized as one of the global major leading industry players in Synthetic Biology by third-party market researchers.
- Contact
Let’s build your custom synthetic biology solution—contact us today to get started.
SBS Genetech © Copyright 2000-2026
from China, for the World
for Superior Biology Services since 2000